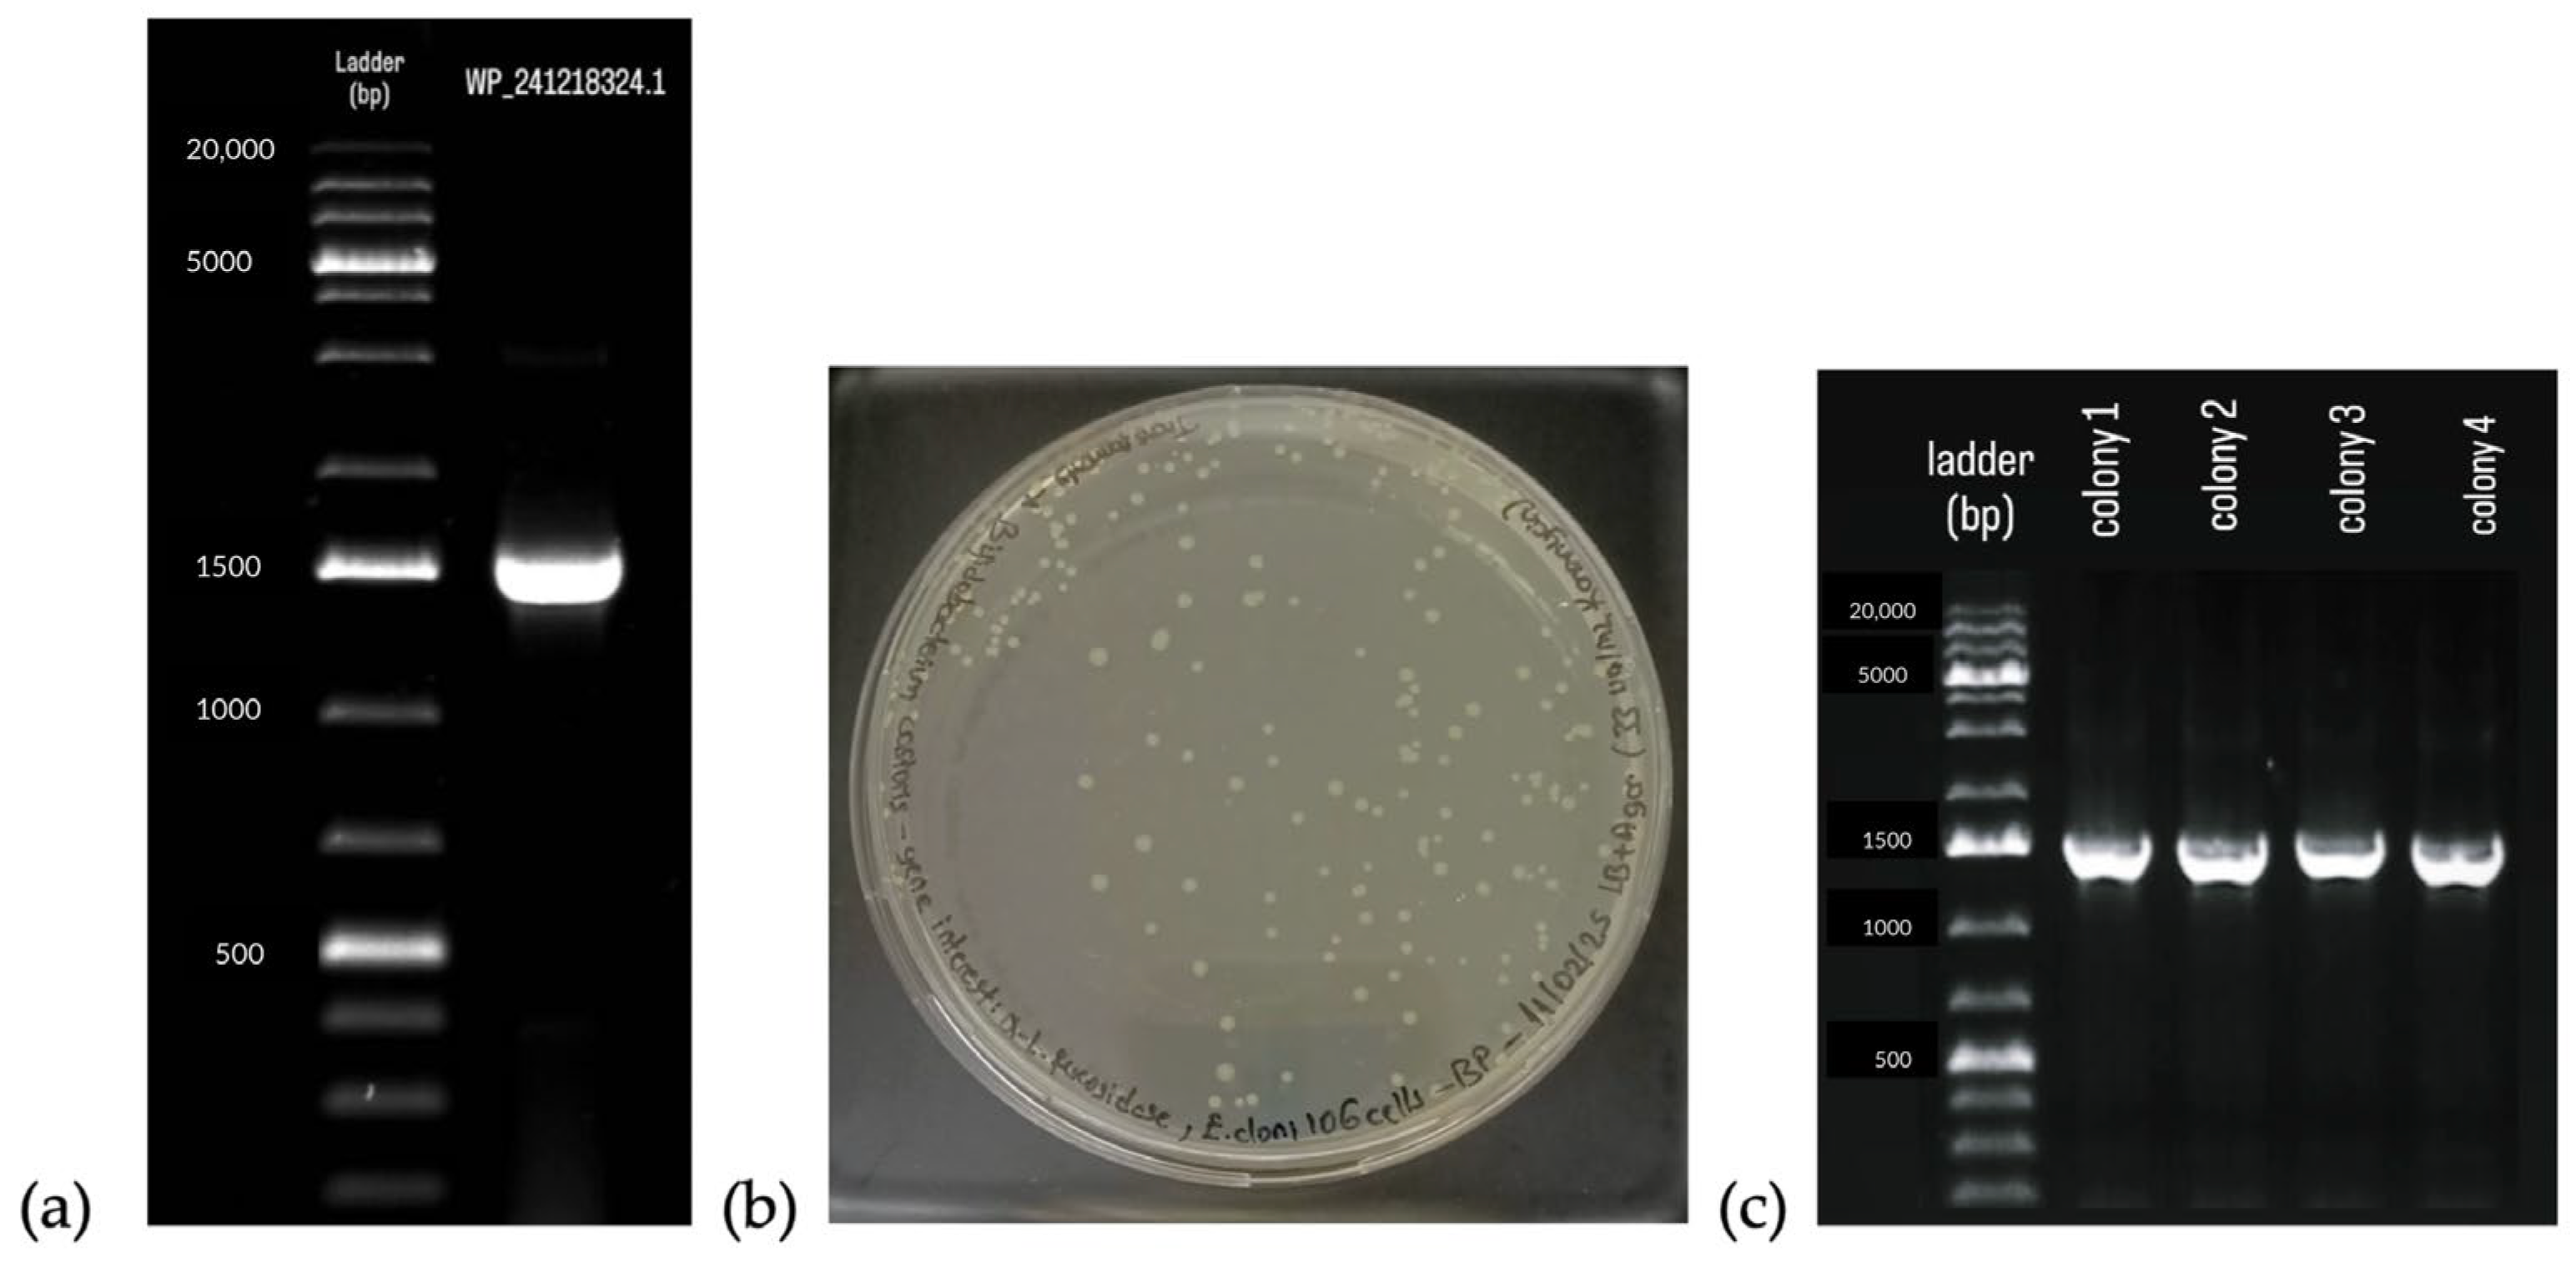

Recombinant Production and Characterization of a Novel α-L-Fucosidase from Bifidobacterium castoris
Abstract
1. Introduction
2. Results
2.1. Cloning of α-L-Fucosidase
2.2. α-Fucosidase Production
2.3. Confirmation of Recombinantly Produced α-L-Fucosidase Activity and Determination of Optimum Reaction Conditions
3. Discussion
4. Materials and Methods
4.1. Materials
4.2. Methods
4.2.1. Bacteria and Media
4.2.2. In Silico Analysis
4.2.3. Cloning, Expression and Purification α-L-Fucosidase
4.2.4. Enzyme Activity Measurement and Determination of Optimum Reaction Conditions
4.2.5. Statistical Data Analysis
5. Conclusions
Author Contributions
Funding
Institutional Review Board Statement
Informed Consent Statement
Data Availability Statement
Conflicts of Interest
Appendix A

References
- Bathula, C.; Ghosh, S.; Hati, S.; Tripathy, S.; Singh, S.; Chakrabarti, S.; Sen, S. Bioisosteric Modification of Known Fucosidase Inhibitors to Discover a Novel Inhibitor of α-l-Fucosidase. RSC Adv. 2017, 7, 3563–3572. [Google Scholar] [CrossRef]
- Marionneau, S.; Cailleau-Thomas, A.; Rocher, J.; Le Moullac-Vaidye, B.; Ruvoën, N.; Clément, M.; Le Pendu, J. ABH and Lewis Histo-Blood Group Antigens, a Model for the Meaning of Oligosaccharide Diversity in the Face of a Changing World. Biochimie 2001, 83, 565–573. [Google Scholar] [CrossRef] [PubMed]
- Matzhold, E.M.; Berghold, A.; Bemelmans, M.K.B.; Banfi, C.; Stelzl, E.; Kessler, H.H.; Steinmetz, I.; Krause, R.; Wurzer, H.; Schlenke, P.; et al. Lewis and ABO Histo-Blood Types and the Secretor Status of Patients Hospitalized with COVID-19 Implicate a Role for ABO Antibodies in Susceptibility to Infection with SARS-CoV-2. Transfusion 2021, 61, 2736–2745. [Google Scholar] [CrossRef] [PubMed]
- Fujita, K.; Hatano, K.; Hashimoto, M.; Tomiyama, E.; Miyoshi, E.; Nonomura, N.; Uemura, H. Fucosylation in Urological Cancers. Int. J. Mol. Sci. 2021, 22, 13333. [Google Scholar] [CrossRef]
- Zhang, B.L.; He, N.; Huang, Y.B.; Song, F.J.; Chen, K.X. ABO Blood Groups and Risk of Cancer: A Systematic Review and Meta-Analysis. Asian Pac. J. Cancer Prev. 2014, 15, 4643–4650. [Google Scholar] [CrossRef]
- Zhang, H.; Stephens, L.C.; Kumar, R. Metastasis Tumor Antigen Family Proteins during Breast Cancer Progression and Metastasis in a Reliable Mouse Model for Human Breast Cancer. Clin. Cancer Res. 2006, 12, 1479–1486. [Google Scholar] [CrossRef]
- Wassarman, P.M. Zona Pellucida Glycoproteins. J. Biol. Chem. 2008, 283, 24285–24289. [Google Scholar] [CrossRef]
- Liu, N.; Jin, C.; Zhu, Z.M.; Zhang, J.; Tao, H.; Ge, C.; Yang, S.; Zhang, S. Stage-Specific Expression of A1,2-Fucosyltransferase and A1,3- Fucosyltransferase (FT) during Mouse Embryogenesis. Eur. J. Biochem. 1999, 265, 258–263. [Google Scholar] [CrossRef]
- Okajima, T.; Irvine, K.D. Regulation of Notch Signaling by O-Linked Fucose. Cell 2002, 111, 893–904. [Google Scholar] [CrossRef]
- Haines, N.; Irvine, K.D. Glycosylation Regulates Notch Signalling. Nat. Rev. Mol. Cell Biol. 2003, 4, 786–797. [Google Scholar] [CrossRef]
- Wu, H.; Owen, C.D.; Juge, N. Structure and Function of Microbial α-L-Fucosidases: A Mini Review. Essays Biochem. 2023, 67, 399–414. [Google Scholar] [CrossRef] [PubMed]
- Grootaert, H.; van Landuyt, L.; Hulpiau, P.; Callewaert, N. Functional Exploration of the GH29 Fucosidase Family. Glycobiology 2020, 30, 735–745. [Google Scholar] [CrossRef] [PubMed]
- Koval’ová, T.; Kovaľ, T.; Stránský, J.; Kolenko, P.; Dušková, J.; Švecová, L.; Vodičková, P.; Spiwok, V.; Benešová, E.; Lipovová, P.; et al. The First Structure–Function Study of GH151 α-l-Fucosidase Uncovers New Oligomerization Pattern, Active Site Complementation, and Selective Substrate Specificity. FEBS J. 2022, 289, 4998–5020. [Google Scholar] [CrossRef] [PubMed]
- You, J.; Lin, S.; Jiang, T. Origins and Evolution of the α-L-Fucosidases: From Bacteria to Metazoans. Front. Microbiol. 2019, 10, 1756. [Google Scholar] [CrossRef]
- Ariaeenejad, S.; Gharechahi, J.; Foroozandeh Shahraki, M.; Fallah Atanaki, F.; Han, J.L.; Ding, X.Z.; Hildebrand, F.; Bahram, M.; Kavousi, K.; Hosseini Salekdeh, G. Precision Enzyme Discovery through Targeted Mining of Metagenomic Data. Nat. Prod. Bioprospect. 2024, 14, 7. [Google Scholar] [CrossRef]
- Kondagari, G.S.; Fletcher, J.L.; Cruz, R.; Williamson, P.; Hopwood, J.J.; Taylor, R.M. The Effects of Intracisternal Enzyme Replacement versus Sham Treatment on Central Neuropathology in Preclinical Canine Fucosidosis. Orphanet J. Rare Dis. 2015, 10, 143. [Google Scholar] [CrossRef]
- Duranti, S.; Lugli, G.A.; Napoli, S.; Anzalone, R.; Milani, C.; Mancabelli, L.; Alessandri, G.; Turroni, F.; Ossiprandi, M.C.; Van Sinderen, D.; et al. Characterization of the Phylogenetic Diversity of Five Novel Species Belonging to the Genus Bifidobacterium: Bifidobacterium castoris Sp. Nov., Bifidobacterium callimiconis Sp. Nov., Bifidobacterium goeldii Sp. Nov., Bifidobacterium samirii Sp. Nov. and Bifidobacterium dolichotidis Sp. Nov. Int. J. Syst. Evol. Microbiol. 2019, 69, 1288–1298. [Google Scholar] [CrossRef]
- Kujawska, M.; Raulo, A.; Millar, M.; Warren, F.; Baltrūnaitė, L.; Knowles, S.C.L.; Hall, L.J. Bifidobacterium castoris Strains Isolated from Wild Mice Show Evidence of Frequent Host Switching and Diverse Carbohydrate Metabolism Potential. ISME Commun. 2022, 2, 20. [Google Scholar] [CrossRef]
- Ashida, H.; Miyake, A.; Kiyohara, M.; Wada, J.; Yoshida, E.; Kumagai, H.; Katayama, T.; Yamamoto, K. Two Distinct α-L-Fucosidases from Bifidobacterium bifidum Are Essential for the Utilization of Fucosylated Milk Oligosaccharides and Glycoconjugates. Glycobiology 2009, 19, 1010–1017. [Google Scholar] [CrossRef]
- Curiel, J.A.; Peirotén, Á.; Landete, J.M.; Ruiz de la Bastida, A.; Langa, S.; Arqués, J.L. Architecture Insight of Bifidobacterial α-l-Fucosidases. Int. J. Mol. Sci. 2021, 22, 8462. [Google Scholar] [CrossRef]
- Martínez Gascueña, A.; Wu, H.; Wang, R.; Owen, C.D.; Hernando, P.J.; Monaco, S.; Penner, M.; Xing, K.; Le Gall, G.; Gardner, R.; et al. Exploring the Sequence-Function Space of Microbial Fucosidases. Commun. Chem. 2024, 7, 137. [Google Scholar] [CrossRef]
- Liu, P.; Chen, X.; Cao, X.; Wang, Y.; Gao, Y.; Xu, L.; Jiang, X.; Xiao, M. Semi-Rational Engineering of an α-L-Fucosidase for Regioselective Synthesis of Fucosyl-N-Acetylglucosamine Disaccharides. Food Chem. Mol. Sci. 2025, 10, 100244. [Google Scholar] [CrossRef]
- Liu, P.; Zhang, H.; Wang, Y.; Chen, X.; Jin, L.; Xu, L.; Xiao, M. Screening and Characterization of an α-L-Fucosidase from Bacteroides Fragilis NCTC9343 for Synthesis of Fucosyl-N-Acetylglucosamine Disaccharides. Appl. Microbiol. Biotechnol. 2020, 104, 7827–7840. [Google Scholar] [CrossRef]
- Zhang, Z.; Li, Y.; Wu, M.; Gao, Z.; Wu, B.; He, B. Identification and Characterization of a Novel α-L-Fucosidase from Enterococcus Gallinarum and Its Application for Production of 2′-Fucosyllactose. Int. J. Mol. Sci. 2023, 24, 11555. [Google Scholar] [CrossRef]
- Schultz-Johansen, M.; Stougaard, P.; Svensson, B.; Teze, D. Characterization of Five Marine Family 29 Glycoside Hydrolases Reveals an α-L-Fucosidase Targeting Specifically Fuc(A1,4)GlcNAc. Glycobiology 2022, 32, 529–539. [Google Scholar] [CrossRef] [PubMed]
- Dong, S.; Chang, Y.; Shen, J.; Xue, C.; Chen, F. Purification, Expression and Characterization of a Novel α-L-Fucosidase from a Marine Bacteria Wenyingzhuangia fucanilytica. Protein Expr. Purif. 2017, 129, 9–17. [Google Scholar] [CrossRef] [PubMed]
- Moya-Gonzálvez, E.M.; Zeuner, B.; Thorhallsson, A.T.; Holck, J.; Palomino-Schätzlein, M.; Rodríguez-Díaz, J.; Meyer, A.S.; Yebra, M.J. Synthesis of Fucosyllactose Using α-L-Fucosidases GH29 from Infant Gut Microbial Metagenome. Appl. Microbiol. Biotechnol. 2024, 108, 338. [Google Scholar] [CrossRef] [PubMed]
- Turroni, F.; Bottacini, F.; Foroni, E.; Mulder, I.; Kim, J.H.; Zomer, A.; Sánchez, B.; Bidossi, A.; Ferrarini, A.; Giubellini, V.; et al. Genome Analysis of Bifidobacterium Bifidum PRL2010 Reveals Metabolic Pathways for Host-Derived Glycan Foraging. Proc. Natl. Acad. Sci. USA 2010, 107, 19514–19519. [Google Scholar] [CrossRef]
- Arzamasov, A.A.; Nakajima, A.; Sakanaka, M.; Ojima, M.N.; Katayama, T.; Rodionov, D.A.; Osterman, A.L. Human Milk Oligosaccharide Utilization in Intestinal Bifidobacteria Is Governed by Global Transcriptional Regulator NagR. mSystems 2022, 7, e0034322. [Google Scholar] [CrossRef]
- Morales-Contreras, J.A.; Rodríguez-Pérez, J.E.; Álvarez-González, C.A.; Martínez-López, M.C.; Juárez-Rojop, I.E.; Ávila-Fernández, Á. Potential Applications of Recombinant Bifidobacterial Proteins in the Food Industry, Biomedicine, Process Innovation and Glycobiology. Food Sci. Biotechnol. 2021, 30, 1277–1291. [Google Scholar] [CrossRef]
- Usvalampi, A.; Ruvalcaba Medrano, M.; Maaheimo, H.; Salminen, H.; Tossavainen, O.; Frey, A.D. Production and Characterization of Aspergillus Niger GH29 Family α-Fucosidase and Production of a Novel Non-Reducing 1-Fucosyllactose. Glycoconj. J. 2020, 37, 221–229. [Google Scholar] [CrossRef]
- Miletti, L.C.; Almeida-de-Faria, M.; Coli, W.; Alves, M.J.M. Immunocytochemical and Biochemical Detection of Alpha-L-Fucosidase in Trypanosoma Cruzi. Braz. J. Med. Biol. Res. 2003, 36, 595–603. [Google Scholar] [CrossRef]





| Temperature (°C) | pH | Mean Activity ± SD (U/mg) | Tukey p-Value |
|---|---|---|---|
| 24 | 3.0 | 0.001 ± 0.004 | <0.001 |
| 24 | 4.5 | 0.033 ± 0.004 | <0.001 |
| 24 | 5.5 | 0.189 ± 0.004 | - |
| 24 | 7.0 | 0.034 ± 0.004 | <0.001 |
| 24 | 8.0 | 0.006 ± 0.004 | <0.001 |
| 37 | 3.0 | 0.001 ± 0.004 | <0.001 |
| 37 | 4.5 | 0.038 ± 0.004 | <0.001 |
| 37 | 5.5 | 0.242 ± 0.004 | - |
| 37 | 7.0 | 0.064 ± 0.004 | <0.001 |
| 37 | 8.0 | 0.009 ± 0.004 | <0.001 |
| 42 | 3.0 | 0.001 ± 0.004 | <0.001 |
| 42 | 4.5 | 0.022 ± 0.004 | <0.001 |
| 42 | 5.5 | 0.264 ± 0.004 | - |
| 42 | 7.0 | 0.084 ± 0.004 | <0.001 |
| 42 | 8.0 | 0.009 ± 0.004 | <0.001 |
Disclaimer/Publisher’s Note: The statements, opinions and data contained in all publications are solely those of the individual author(s) and contributor(s) and not of MDPI and/or the editor(s). MDPI and/or the editor(s) disclaim responsibility for any injury to people or property resulting from any ideas, methods, instructions or products referred to in the content. |
© 2025 by the authors. Licensee MDPI, Basel, Switzerland. This article is an open access article distributed under the terms and conditions of the Creative Commons Attribution (CC BY) license (https://creativecommons.org/licenses/by/4.0/).
Share and Cite
Pekdemir, B.; Karav, S. Recombinant Production and Characterization of a Novel α-L-Fucosidase from Bifidobacterium castoris. Int. J. Mol. Sci. 2025, 26, 9344. https://doi.org/10.3390/ijms26199344
Pekdemir B, Karav S. Recombinant Production and Characterization of a Novel α-L-Fucosidase from Bifidobacterium castoris. International Journal of Molecular Sciences. 2025; 26(19):9344. https://doi.org/10.3390/ijms26199344
Chicago/Turabian StylePekdemir, Burcu, and Sercan Karav. 2025. "Recombinant Production and Characterization of a Novel α-L-Fucosidase from Bifidobacterium castoris" International Journal of Molecular Sciences 26, no. 19: 9344. https://doi.org/10.3390/ijms26199344
APA StylePekdemir, B., & Karav, S. (2025). Recombinant Production and Characterization of a Novel α-L-Fucosidase from Bifidobacterium castoris. International Journal of Molecular Sciences, 26(19), 9344. https://doi.org/10.3390/ijms26199344

